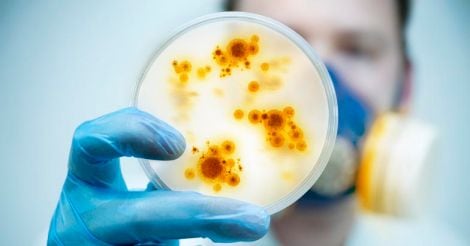
Heal Thy Self | Can mental illness be caused by an infection?

Once upon a time, not so very long ago (and this is a true story, by the way), there was a little boy called Seth (his real name) and his mother Jane (also her real name) who stayed in Maryland, U.S. Seth was a quiet 10-year-old whose small rebellions rarely went beyond balking at bedtime or protesting limits on his Internet use.
Then suddenly, virtually overnight, it seemed, Jane found herself up against non-stop whining and arguing from Seth. For one thing, he wouldn’t eat his meals, complaining that the food “looked funny”, and what if he were poisoned, he could die! His puzzled mother at first tried to reassure him, but had to give up after two-hour stand-offs during which Seth just pushed his food around his plate.
Then, he wouldn’t go to sleep. When Jane came into his room to say goodnight, she found him cowering in one corner of the bed, whimpering that rats would attack him in the night. “There are no rats here!” his mother snapped. Then, seeing the look in his eyes, she suddenly realized that, behind his cranky complaints, there was real terror. She took him to sleep in her bedroom, dozed off, then woke with a start to find a deep depression in the bed where Seth had lain, and the sound of running water. She broke into a run... and found Seth at the sink washing his hands with a new bar of soap that he had worn down to a shard, a nail brush and a hand towel. His skin was raw and reddened. He didn’t even seem to hear her pleas to stop. She knew what she had to do.

Read more : Heal Thy Self | The only winning move in the blame game
By the time they arrived at the emergency room of the hospital, Seth’s lower lip was twitching. Suddenly, he leaped up from his seat and began picking up every piece of paper from the floor with his sore hands, his head bobbing all the while. Then, stopping abruptly, he ran to Jane, pulling at her frantically: “Mommy, mommy! They’re coming to kill us, we’ve got to go. Now!” By this time, Jane was bordering on panic.
The pediatrician diagnosed Seth with Obsessive-Compulsive Disorder (OCD). He explained to Jane that OCD was characterized by severe anxiety and that compulsive behaviours such as hand-washing helped to allay the anxiety. But Jane couldn’t shake off her feeling that Seth’s symptoms had come on practically overnight. Was that normal in OCD, she asked the doctor. No, he said, Seth had probably been developing the symptoms for some time, but she had been too close to him to notice.
But Jane was not convinced. She knew her son, and this sudden transformation just seemed “biological” to her, something that had “happened” to Seth, not something that he “was”. The only recent unusual event she could remember happening to him was a series of bouts with a sore throat. She remembered that two of his classmates had recently recovered from strep infection, and she also remembered, with some guilt, that she hadn’t taken Seth to a doctor. She asked the pediatrician whether Seth would not have developed OCD if he had been treated with an antibiotic for his throat infection. He smiled indulgently and reassured her that Seth’s problem was psychological, and had nothing whatsoever to do with a sore throat.

Most pediatricians at the time would have agreed. But Jane just couldn’t rid herself of the conviction that there was a connection between Seth’s sore throat and his changed behaviour. She took her worries to Seth’s pediatrician, expecting they would once again be shrugged off. But, fortunately for Seth and Jane, the pediatrician happened to be Susan Swedo, who was attached to the National Institute of Mental Health (NIMH). Swedo listened, intrigued, because Seth’s story was unusual in ways that sounded familiar to her – i.e., other children who had also suddenly developed OCD symptoms shortly after a bout with strep throat.
Swedo today gives the credit to Jane for what followed as an NIMH team, led by Swedo, carried out path-breaking research in 1998 that established a surprising cause for OCD in some children: an abnormal immune response to streptococcal infections such as strep throat.”It was a mom who first made the connection, not doctors,” Swedo says today.
The idea that you can “catch” a mental illness through infection may sound improbable. As a matter of fact, it’s neither a novel occurrence nor a revolutionary notion. For centuries, we have known of mental illnesses brought on by bacteria or viruses or parasites. Two instances are rabies and syphilis. Rabies attacks areas in the brain, and as it spreads the person can show bizarre behaviour, hallucinate, become agitated, confused and uncontrollably excited. In late-stage syphilis, the infection brings on “paresis”. The brain is severely damaged, causing significant loss of memory, delusions, mania and personality changes. In fact, late-stage syphilis was frequently treated as a mental disorder until the 1940s when the new wonder drug, penicillin, successfully cured the bacterial infection and scores of syphilis sufferers exited the doors of asylums where they had been languishing for years as “schizophrenics”.
Read more: Heal Thy Self | Read my lips
What is different today is that the scientific evidence is growing that infections could sometimes be the cause of a whole range of classical mental illnesses, including depression, bipolar disorder, OCD, anorexia nervosa and schizophrenia. The evidence comes from study findings, clinical observations and anecdotal evidence (not to be discounted at all, as stories like Seth’s show).
There is enough evidence now for us to re-consider the current premise that mental illness is triggered only by genes, chemical imbalances in the brain and environmental stressors such as sexual or physical abuse, abandonment or heavy drug use. A clutch of micro-organisms has been associated with mental illness, including those that cause chicken pox, shingles, certain strains of herpes, e. Coli infections, strep throat, toxoplasmosis and Borna disease.
At a guesstimate, mental-health researchers say that 10 to 15 percent of mental illness is associated with infection. There are a few outliers who say the number is much more – or less.
How does infection bring on a mental illness?
Two possible pathways have been suggested. One is that the invading pathogen directly attacks the brain, as in rabies or syphilis.
The other is an indirect route: it is not the invading pathogen, but the body’s powerful immune response to the infection that initiates a process in which the brain comes under attack, bringing on signs and symptoms that present as mental illness. One kind of immune response triggered by infection is inflammation. This inflammatory response can stay active for weeks, months or years and result in collateral damage – including damage to the brain.
Another way that the immune response can go awry is that the antibodies it produces to attack the invading pathogen also begin to attack the body’s healthy tissues, including the brain. These antibodies, which are, in effect, turned against the self, are known as auto-immune antibodies. And the brain is now being viewed as a highly vulnerable immunological target. In effect, mental illness might sometimes be an unfortunate price we pay for our powerful immune defenses.
Here’s a closer look at a few of the mental disorders in which infection has been implicated as the trigger in some cases.
Read more: Heal Thy Self | Work smart, not late
Depression and bipolar disorder: We now have a burgeoning body of research (including post-mortem studies) that have linked depression with elevated markers of inflammation in the body. One is a huge Danish study in 2013 which looked at the medical records of over 3 million people. It found that any history of hospitalization for infection was associated with a 62 percent increased risk of later developing a mood disorder like depression or bipolar. The Danish study also reported that a history of an auto-immune disorder (e.g., rheumatoid arthritis, multiple sclerosis, Type 1 diabetes) increases the risk of a future mood disorder by 45 percent.

The Danish study merits serious attention because Denmark (like Sweden and Finland) keeps detailed, cradle-to-grave medical records on millions of citizens. This enables large-scale studies to be undertaken in these countries.
More recently, a study from Canada last year found that people with depression had about a 30% increase in inflammation in the brain, compared to those study participants who did not have depression.
It is also interesting that common medical conditions like diabetes, obesity and cancer, all of which are associated with chronic inflammatory and immunological abnormalities, can also bring on mood disorders like depression and bipolar.
Schizophrenia: Numerous studies, including several large population studies, indicate that a parasite excreted by cats in feces may be the cause of both major and minor mental illness in humans. One of the major illnesses is schizophrenia in people with a vulnerable genetic make-up. In those who do not have this vulnerability, the parasitic infection can affect personality – for example, leading to increased reckless behaviour in men, making them more likely to take risks and cutting down reaction times; infected men, studies have found, end up with more car accidents as a result of reckless driving than non-infected men.

The infection is called Toxoplasmosis, and the culprit parasite is Toxoplasma gondii (or T. Gondii or Toxo, for short). Handling cat litter is the most common way that the infection jumps from the host species, the cat, to humans.
Some scientists, however, have questioned the strength of the link between T. Gondii and mental illness in humans.
Anorexia: The earliest pointers to a link between anorexia and bacterial infections came from studies that found that eating disorders can develop on the heels of an infection.
Then researchers at the Karolinski Institute in Sweden found high levels of antibodies in those with anorexia. These were antibodies generated to fight common bacteria such as E. coli (which causes intestinal infections) and H. Pylori (which causes ulcers in some people). These antibodies, they suggested, could have a role in attacking chemical messages from the brain that control appetite.
Last year, a team of UK scientists, writing in the highly-respected journal, Medical Hypotheses, suggested that anorexia may be caused by bacteria that attack the brain’s limbic area (which houses the emotion center), inducing extremes of emotion, in particular disgust and fear. In the vulnerable minds of teenage girls (the most common victims of anorexia), these extremes of emotion then get linked to culturally determined ideas of what is, and what is not, the ideal body shape and size. It is then a small step for disgust and fear to be directed to food and obesity which the fashion industry currently demonizes.
The scientists plan to pursue this research strand further. If proven, the fascinating hypothesis opens up new avenues of treatment. For example, transfusing immune cells from the blood of healthy people could help reverse the most severe cases of anorexia.
Read more: Heal Thy Self | Regain the trust of your teenager
Childhood OCD: Swedo’s research was followed by other studies in different countries that confirmed that some children who develop OCD do so in the wake of a streptococcal infection. Some of this research has found that strep doubles a child’s risk of developing OCD within 3 months; multiple strep infections within a year triple the risk.
When OCD develops in kids on the heels of a strep infection, it follows a pattern that is different from regular OCD. Regular OCD begins with a few anxieties which gradually increase in severity over days, weeks or, most likely, months; in contrast, OCD that follows strep develops abruptly and dramatically – overnight, as it were.

Mental illness that begins in the womb: The possibility that the fetus is at risk for mental illness first emerged with an observation by Finnish researchers in 1988 that children born during the 1957 Asian flu epidemic had high rates of schizophrenia. But flu viruses do not cross the placenta – so, they cannot reach the fetus to cause damage. What happens, it seems, is that the mother’s immune system responds to the flu infection by creating a storm of “cytokines” (small signalling proteins) that can cause cells to stop growing. How much damage is done to the fetal brain depends partly on which stage of the pregnancy the infection strikes: if it happens in the later stages, the damage may be more subtle. Also, although children affected by the pregnant mother’s antibodies may seem “different” during childhood (e.g., they may sit up later and lag behind other kids in speech and overall motor development), the hallucinations, delusions and paranoia of true schizophrenia do not normally emerge until late adolescence, when there is a lot of re-arranging and pruning taking place in the brain.
The influenza virus apart, evidence has been increasing for years that mental illness in the child may be linked to the pregnant mother’s exposure to other viruses like rubella, herpes and cytomegalovirus, and to parasites like T. gondii.
Besides schizophrenia, other mental illnesses like bipolar disorder and autism have also been linked to viral infections during pregnancy.
For more on this, read: Heal Thy Self | How to ensure your unborn baby’s mental health
Where do we go from here?

For the most part, the research so far has shown associations, but not watertight cause-and-effect between infection and mental illness. But the positive correlations are too numerous to ignore. While studies continue apace to better understand how the immune system “talks to” the brain, the search for new avenues of treatment also gains momentum. One question to which answers are being sought is: If inflammation apparently plays such an important role in triggering mental illness, do anti-inflammatory drugs have a role to play in treatment? So far, trials testing these drugs have produced results that are overall mixed or underwhelming.
Two treatments that Swedo proposed for children who develop OCD following a strep infection come with their own risks. One of them, long-term antibiotic therapy, can promote the development of antibiotic-resistant organisms. Another, treatment with immune-suppressants, puts children at risk for serious infections.
But there a number of commonsensical, non-drug strategies that we can put to work even as we await the outcome of further research. For instance, a sore throat in a child should not be ignored as something that will pass. Although OCD triggered by a strep infection happens to a small number of children, quick treatment with antibiotics can often reverse the problem.
Pregnant women should avoid exposure to someone who has a flu, and also avoid spending time with people in closed places (like movie theaters) where contagion can spread more easily. It’s also important for a pregnant woman as well as other family members to wash hands with soap and water frequently.
Read more: Heal Thy Self | How well do you handle the bad news?

A pregnant woman should not clean out a cat’s litter box. And others also need to exercise care while doing so: using gloves; also, a mask, because litter dust can scatter as you’re scraping it off the box or transferring it into a trash bag; and washing the box inside and out. And, of course, after you’re done with the clean-up, washing your hands with soap and water is key.
When you get right down to it, while the science of psychiatry has a long way to go, there are a number of approaches that appear to have anti-inflammatory effects without harmful side-effects – for instance, exercise, healthy sleep habits and meditation. Research from the University of California at San Diego, published this year, reports that just 20 minutes of moderate exercise can produce an anti-inflammatory response; this backs earlier findings on the anti-inflammatory effects of exercise. Meditation has been linked to the reduction of a key inflammation marker. And, loss of sleep – even for a single night – has been found to lead to inflammation flare-ups. Yes, the basics cannot be discounted.
(The author is a former editor of 'Health & Nutrition' magazine, and now works as a counseling therapist)



























 The answer to this question may come as a shocking surprise to may, writes Nirmala Ferrao.
The answer to this question may come as a shocking surprise to may, writes Nirmala Ferrao.